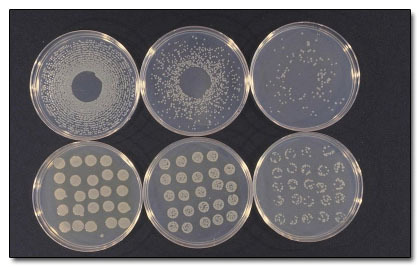
iE 415

6 Ways Bacteria Will Prevent the Apocalypse
Not all bacteria is of the flesh-eating, "kill it before it kills you" variety. Some of it is actually good for you. Maybe you've seen the commercials where it helps Jamie Lee Curtis poop, for instance.
But even more beneficial than that, there are some strains of bacteria that not only can perform massive, superhero-level feats, but are probably going to be what stands between us and an apocalyptic future. Feats like ...
Controlling the Weather

If you've ever been unlucky enough to get caught in a hailstorm then you probably know that it's goddamn painful. And while at the time you may have been rhetorically asking the heavens why they were so insistent firing tiny balls of ice at your face, now you have an actual answer: Nearly 85 percent of all hailstones have bacteria at the center.

"I have come here to chew bubblegum and fuck up new cars. And I'm all out of bubblegum."
The bacteria is called Pseudomonas syringae and when it's kicked up into the air, it collects condensation fury, forming water droplets (or in the case of hail, death pellets). Generally the moisture in clouds needs something to cling around in order to create precipitation, and the syringae provide the perfect nucleus.
Pseudomonas syringae, seen here biding its time.
So how does this information help us? Well it could allow us to weaponize water, destroying the windshields of our most hated enemies. Or we could use it to stop droughts.
What? How?
We know that this particular bacteria causes water to freeze about 7 degrees Fahrenheit higher than usual, which means it can create snow and ice in slightly warmer temperatures. For that reason, mountain resorts have been using Pseudomonas syringae bacteria to make fake snow since the late '80s. But for anyone who's not jetsetting to Aspen this winter, there are more practical applications as well. Scientists say it's possible that planting crops already infected with these bacteria may help overcome droughts by inducing rain.

The scientists assured reporters that they had "no plans for supervillainy" and then
cackled like mad men for 12 solid minutes.
The bacteria is whipped up into the air the same way the pollen of plants would be, except once it climbs high in the atmosphere, the Pseudomonas syringae encourages rain in the area. Even if you're not on board with the idea of genetically engineering plants to be infected with bacteria, researchers think that just planting crops that encourage the bacteria would have a similar effect. And likewise, planting crops that the bacteria doesn't like might encourage droughts. So there might come a day when solving the world's water problems is just a matter of ordering up some manipulative microbes.

And practical jokes are about to take a big step up.
Colonizing Other Planets

An unspoken rule among party-goers is that anyone left at the end of the night helps to clean up a little, so naturally everybody tries to leave early to avoid dealing with the mess. Well what if we could apply that same lack of accountability to Earth? If we never solve the energy crisis and don't get a handle on greenhouses gases, it may be possible in the future to just leave for another planet. Surely we won't screw that one up, right?

Second planet's a charm!
Apparently, a bacteria called Deinococcus radiodurans is going to help us along the way.
What? How?
Deinococcus radiodurans, which is nicknamed "Conan the Bacterium" is famous for its ability to not die. It shrugs off an astronomical amount of radioactivity, up to 1.5 million Rads, which is equivalent to 1.5 million Teenage Mutant Ninja Turtles, or 3,000 times more radiation than it takes to kill a human. It's also about 750,000 times more than the maximum daily measured radiation on Mars. See where we're going with this?

How many of these do we have to eat to gain their powers?
You may know that "terraforming" is the process of making another planet, like Mars, more Earth-like before we even get there. Obviously that's difficult if not impossible if the work involves millions of humans in bulky suits and hundreds of ships taking them back and forth. But microbes like Deinococcus radiodurans open up the possibility of sending a bunch of them spilling out onto the Martian surface and letting them do the work for us. For instance, even if Mars had our atmosphere, we couldn't grow plants there because the soil is toxic. But we have decoded the genome of Deinococcus radiodurans, and therefore could one day engineer a version that would change the composition of the Martian soil, making it plant-friendly.

Apparently Mars needs bacteria, not women.
But there are broader applications; just examining the way the microbe resists damage from radiation tells us a lot about how to engineer other things to do the same (radiation is normally harmful because it damages DNA, and Deinococcus radiodurans has a mechanism for rapidly repairing that damage). We could theoretically do everything from engineering goods to survive the long trip through space to genetically altering the astronauts themselves to be impervious supermen. HOW COULD THAT POSSIBLY GO WRONG?

"This place is awful. Can't we just go take over Earth?"
Eating Battleships

The biggest problem with ships is that when they're old and unusable, there's nowhere to retire them other than the bottom of the ocean. The U.N. estimates that over 3 million ships are located on the ocean floor, with fewer than a thousand that anyone has any plans to clean up. And that's not even covering all the defunct oil rigs down there. As cool as it might be to go exploring sunken battleships on the bottom of the sea in search of treasures and corpses, what we really need is a way to clean up the mess.

Drain cleaner and a Super Soaker?
Enter the Halomonas titanicai, a bacteria that loves eating metal and could do all the cleaning up for us.
What? How?
Before Titanic was a convenient way to see Kate Winslet naked, it was actually a ship. And had anyone known how many movies she would get naked in after Titanic, we probably could have avoided the whole thing. Anyway, the real ship sank in 1912, where it sat undisturbed for over 70 years. Well, "undisturbed" isn't entirely accurate. During that time, a bacteria sprouted colonies all over the vessel and they are eating the Titanic.

James Cameron's Oscar is somewhere in there.
These bacteria adhere to metal, then create rust knobs which appear to be slowly devouring the ship. It's good news for anyone who is mildly interested in ocean health, but sadly, bad news for anyone who was substituting an old cruise ship for an actual relationship.

"Just knowing they're together now is enough for me."
Because of the great work the bacteria is doing on the Titanic, researchers don't see any reason we can't use the same cultures to clean up other oil rigs and ships. Or, conversely, knowing exactly how the bacteria eats away at metal can inform how we build boats in the future so that they are stronger. By finding a way to prevent this bacteria from colonizing, we can ensure that oil rigs stay structurally sound for a lot longer. Then again, if one of them collapses and it's resistant to the bacteria, then we're right back where we started with steel trash on the floor of the ocean.

At least this will make a pretty reef.
Fixing Obesity

We at Cracked certainly know that the pie chart on causes of obesity is as complex as it is delicious. We know there are all sorts of contributing factors, like genes and brain stuff and how close the nearest doughnut shop is to your house. We also know that every overweight person can now add bad gut bacteria to the list of excuses for why they can never fix their fat selves.

Those four daily cans of Pringles still deserve top billing though.
After all, your intestines aren't just a food-to-shit conversion chamber turning that Taco Bell fourth meal into ... well Taco Bell is a bad example. Your intestines also play host to about 500 different species of bacteria, and that's a good thing because bacteria break down and absorb the food our bodies can't digest alone. The last thing anyone wants in their belly tube is all the food you ever ate ever, right?

Except maybe Giardia, "the farting death."
Recently, scientists have found that when we eat a high-fat, sugar rich diet, we not only pack in the calories, we also encourage the growth of bacteria called Firmicutes in our intestines, which happen to love Bugles and Twix bars. They love fatty foods so much that they devour it, breaking the compound down until it is sure to be absorbed by the body, like some kind of chubby lovin' specialty bacteria with its own section of Craigslist and everything.

Likes: Marijuana, Super Sized anything and County Fairs.
In a study that changed the diet of lab mice from low-fat, plant based meals to fatty foods, the mice picked up a new set of bad bacteria overnight and started packing on the pounds. They even stayed fat after switching back to low-fat foods. So that's the bad news. Bad bacteria makes you fat. Here's the good news: Good bacteria makes you skinny! Surprise!

If you just keep exposing yourself to bacteria, you're bound to hit the right one eventually.
What? How?
Daily intake of a unique lactic acid bacteria was shown to keep the fat-loving bacteria away, which is great news for people who despise the idea of working out. Scientists tested the effectiveness of Lactobacillus plantarum HEAL19 by feeding it to baby rats every day, even before they were born. Then those rats were fed some high fat, McDonaldsish diet and despite enjoying fatty foods, the rats with the lactic acid bacteria living inside their gut stayed leaner.
So, the theory goes that by intentionally ingesting something that looks like this ...

... regularly and from an early age, you can allow this stuff to colonize inside of you like tiny but stern fat camp councilors that constantly keep obesity in check.
Cleaning up Oil Spills

Thanks to BP, you might have already known that there's a bacteria that eats oil and poops dolphins. It's possible we misread the press release, but we know for certain it can help clean up disastrous spills. What you probably didn't know was that the bacteria is called (ugh ... seriously science?) Alcanivorax borkumensis.

His posture proves the existence of bacterial shame.
Ridiculous names aside, the bacteria is pretty rare in unpolluted waters, but once an oil spill occurs, it shows up like a superhero. We'd equate it to Aquaman, but technically the bacteria is just a little bit better at its job. The microbes start multiplying quickly in the event of a spill, fattening themselves on oil ... but only to a certain point. The BP oil spill overwhelmed the existing oil-eating bacteria and they weren't nearly as helpful as they were for the Exxon Valdez spill in 1989. But some people think they have the answer to that problem.

Sadly, it isn't "electric golf carts for everybody."
What? How?
With fertilizer. Specifically, nitrogen and phosphorous. The same stuff that they're putting on the (nonorganic) crops that are feeding the world could also fertilize the bacteria that loves oil. Adding fertilizer to the water increases the size and number of the bacteria so there are more out there to cut through all that oil.

Also, some of these bacteria poop biodegradable plastic.
Still, the process hasn't exactly been tested in deep waters yet, and one of the main consequences could be an overwhelming amount of algae (which also loves fertilizer). That kind of thick marine vegetation could overpower more fragile species. Still, it's been proven to work well near shores and can still do a whole lot of good.

If only we could design oil-eating wildlife.
Turning Greenhouse Gases into Bricks

We don't need to explain why CO2 is a problem for the environment right now -- it's why the nations of the world are scrambling to reduce emissions before we fry ourselves into a Venusian nightmare.

Your colleagues will still want to turn up the thermostat.
A lot of potential CO2/global warming fixes are on the table, but sometimes just overcoming your enemy isn't enough. Sometimes you want to destroy them and use pieces of them in your buildings and roads just to remind yourself how superior you are.
Well it turns out we can do just that with carbon dioxide.

Finally, we can pollute with a clear conscience.
What? How?
There are two ways that nature deals with CO2: either through photosynthesis in plants which turns out oxygen, or through bacteria which convert CO2 into solid calcium bicarbonate. That kind of "air into stone" transformation sounds like alchemy, but about 40 percent of the chalk cliffs in the world are created by carbon dioxide absorbing microbes. Not only are oxygen and calcium bicarbonate less threatening for humanity and for the world, they are also completely useful to us.

We still say it's probably magic.
A group of Indian scientists have discovered bacteria capable of creating building materials out of the carbon dioxide in the air, essentially creating a chemical reaction that turns a gas into a separate, solid compound. A rock-solid compound.

You can use it to build walls or cut cocaine. It's a miracle compound!
We can use calcium bicarbonate in building materials, agricultural lime, the purification of iron and even antacid tablets. The group of scientists speculates that modern factories could include bacteria chambers to convert the CO2 before it leaves the building. This would allow a factory to produce massive stores of calcium bicarbonate while giving off only low levels of dangerous emissions, thus killing two birds with one chalky stone.
You can read more from Kristi here or on Twitter.
Be sure to check out 5 Horrible Diseases That Changed The World (For the Better). Or learn about 6 Terrifying Diseases That Science Can't Explain.